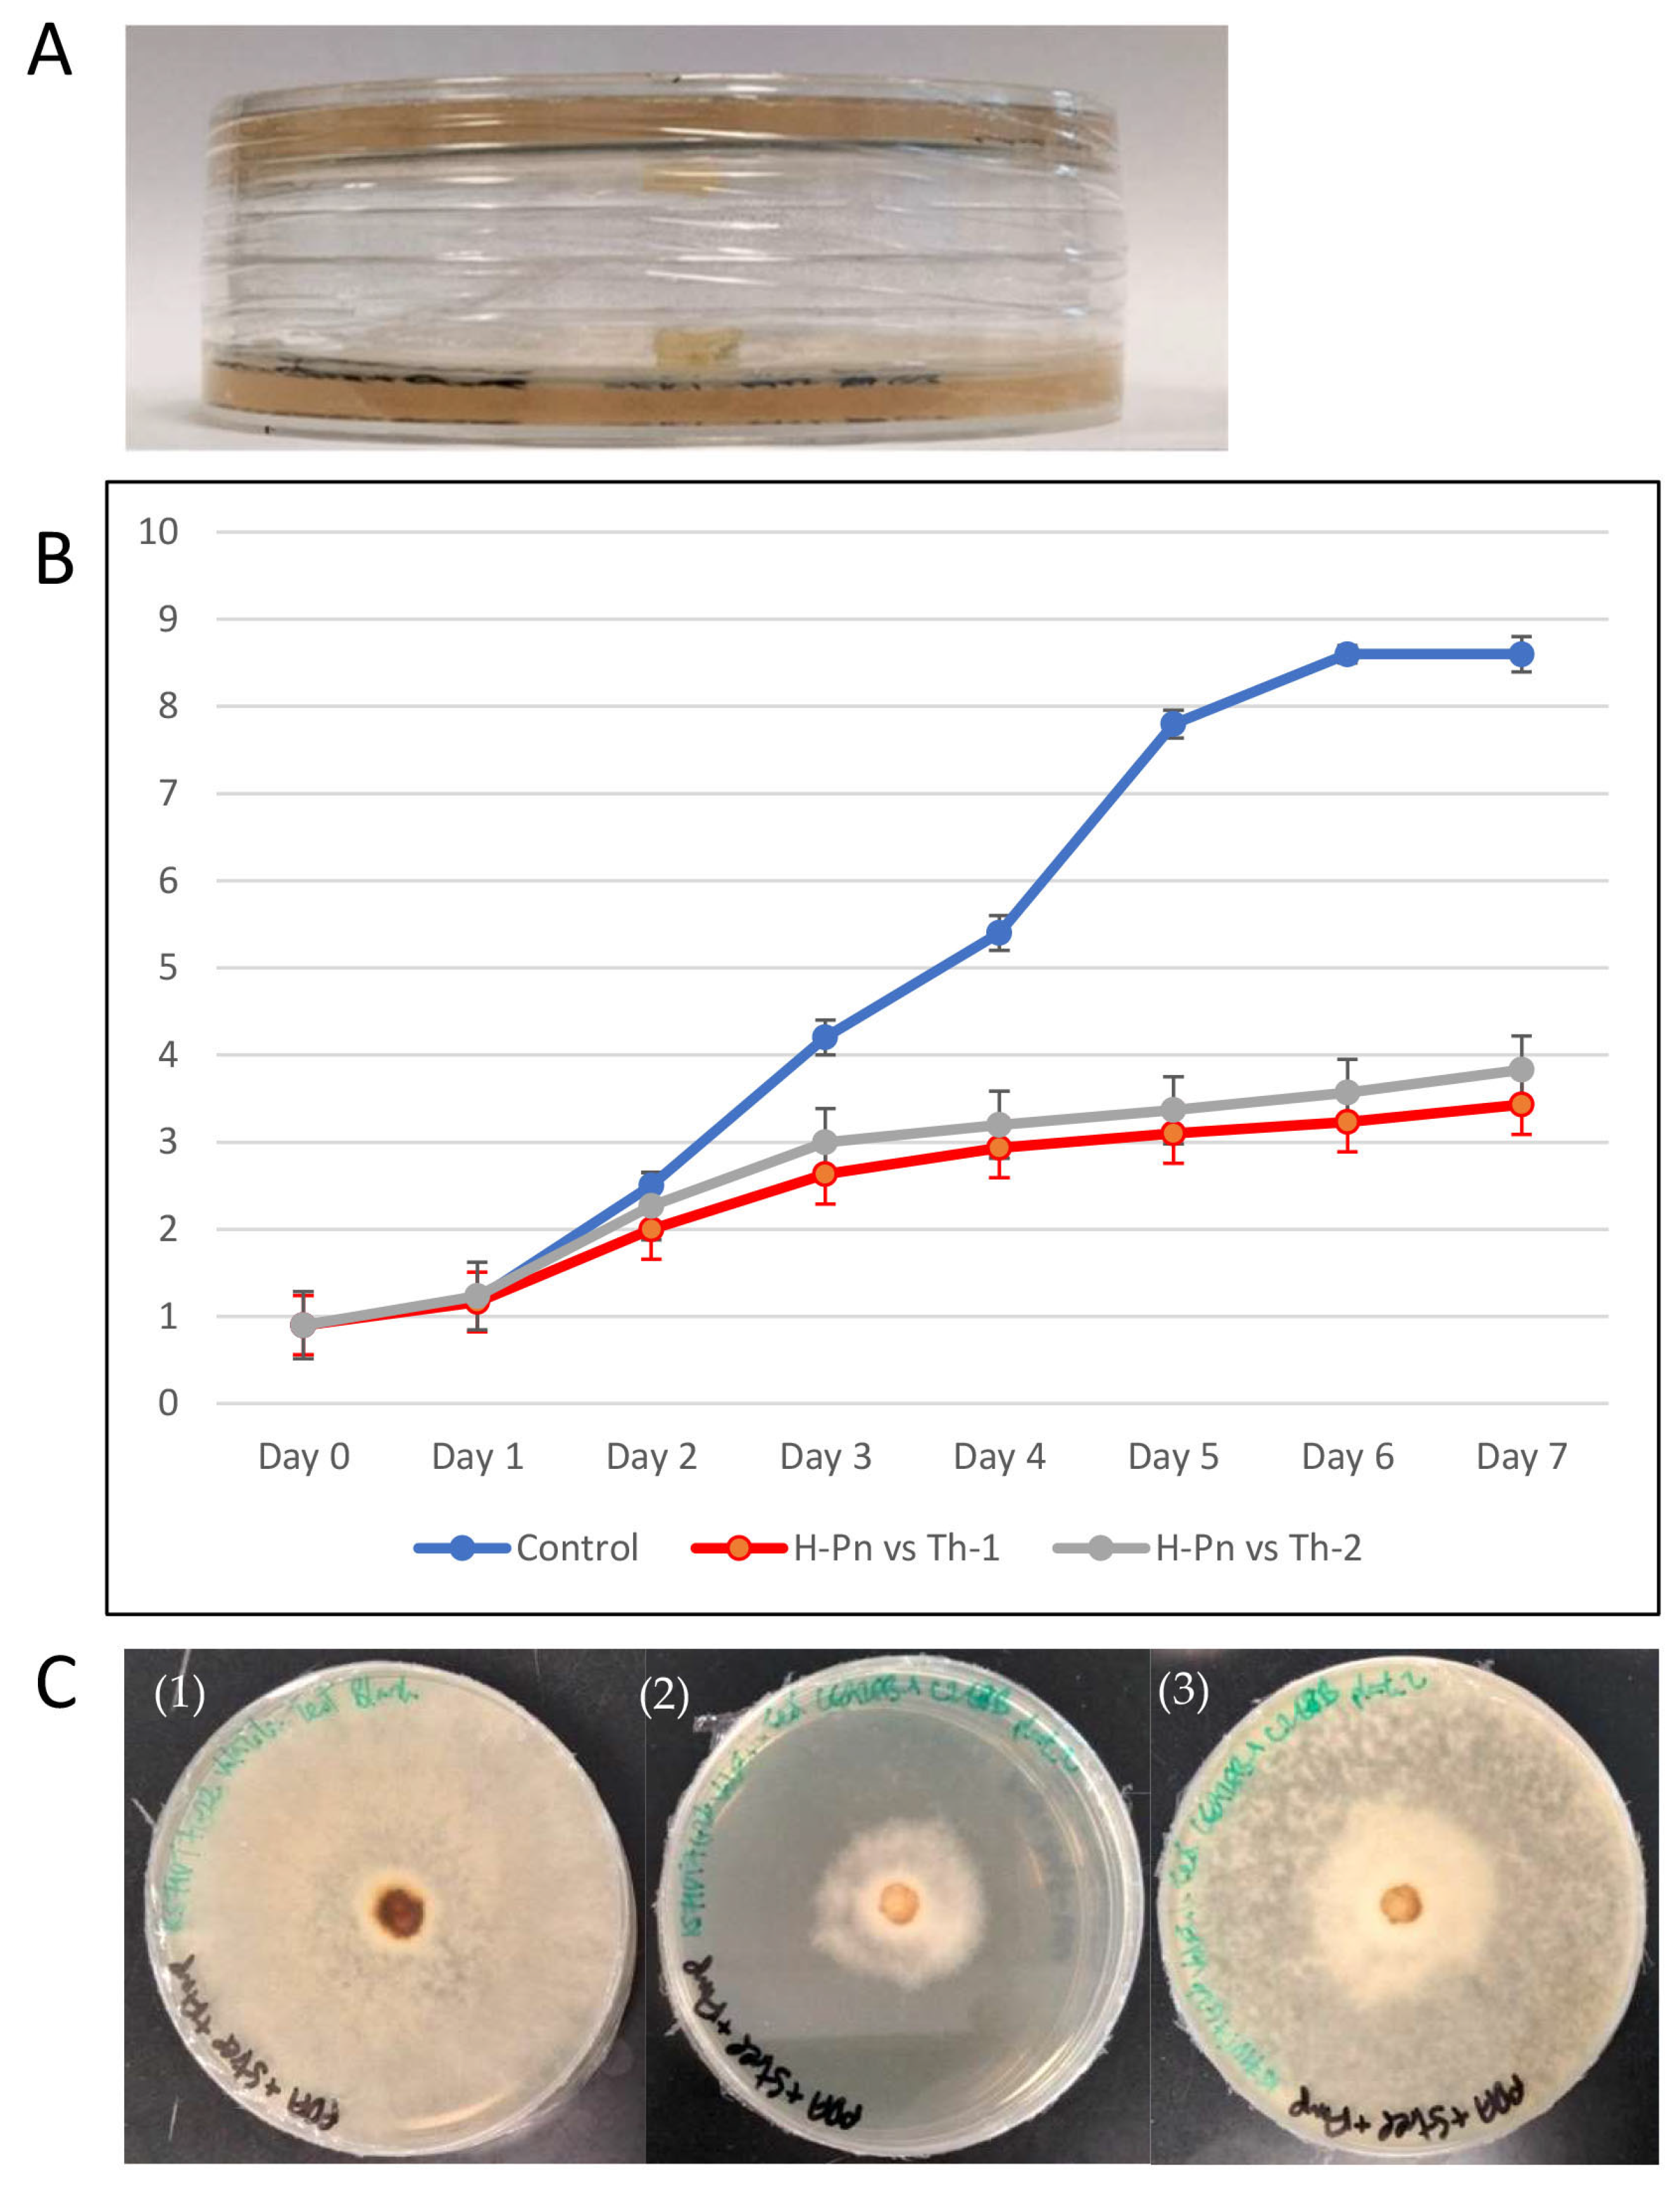
Jof 09 00675 g006 Jof 09 00675 g006

Locally Isolated Trichoderma harzianum Species Have Broad Spectrum Biocontrol Activities against the Wood Rot Fungal Species through Both Volatile Inhibition and Mycoparasitism
Abstract
1. Introduction
2. Materials and Methods
2.1. Culture Media Preparation
2.2. Culturing and Isolation of Fungi
2.3. DNA Extraction from Fungal Cultures
2.4. Barcoding for Fungal Isolates
2.5. Growth Rate Comparison among the Trichoderma Strains
2.6. Dual Culture Assay
2.7. Inhibition Test by Volatile Organic Compound (VOC)
2.8. SPME GC-MS (Solid Phase Microextraction Gas Chromatography–Mass Spectrometry)
2.9. Microscopy Analysis of Fungi Interface
2.10. Statistical Analysis
3. Results
3.1. Identities of Fungal Isolates Were Elucidated by DNA Barcoding
3.2. T. harzianum Strains CE92, SSK1, and W2-5 Selected for Further Study
3.3. Th-1 and Th-2 Displayed Potent Inhibitory Activity against Pathogenic Fungi in a Dual Culture Assay
3.4. Th-1 Releases Fungal Inhibitory Volatiles Phenylethyl Alcohol and Cadina-1,4-diene
3.5. Th-1 Exhibits Mycoparasitic Mycelial Interactions
4. Discussion
4.1. CE92 (Th-1) Is the Best BCA Candidate
4.2. Mechanistic Studies
5. Conclusions
Supplementary Materials
Author Contributions
Funding
Institutional Review Board Statement
Informed Consent Statement
Data Availability Statement
Acknowledgments
Conflicts of Interest
References
- Williamson-Benavides, B.A.; Dhingra, A. Understanding Root Rot Disease in Agricultural Crops. Horticulturae 2021, 7, 33. [Google Scholar] [CrossRef]
- Coque, J.J.R.; Álvarez-Pérez, J.M.; Cobos, R.; González-García, S.; Ibáñez, A.M.; Diez Galán, A.; Calvo-Peña, C. Advances in the control of phytopathogenic fungi that infect crops through their root system. Adv. Appl. Microbiol. 2020, 111, 123–170. [Google Scholar] [CrossRef]
- Ann, P.J.; Chang, T.T.; Ko, W.H. Phellinus noxius Brown Root Rot of Fruit and Ornamental Trees in Taiwan. Plant Dis. 2002, 86, 820–826. [Google Scholar] [CrossRef] [PubMed]
- Chang, T.T. Survival of Phellinus noxius in soil and in the roots of dead host plants. Phytopathology 1996, 86, 272–276. [Google Scholar] [CrossRef]
- Bodah, E.T. Root Rot Diseases in Plants: A Review of Common Causal Agents and Management Strategies. Agric. Res. Technol. Open Access J. 2017, 5, 555661. [Google Scholar] [CrossRef]
- Hong, Y.; Tan, J.Y.; Xue, H.; Chow, M.L.; Ali, M.; Ng, A.; Leong, A.; Yeo, J.; Koh, S.M.; Tang, M.S.Y.; et al. A Metagenomic Survey of Wood Decay Fungi in the Urban Trees of Singapore. J. Fungi 2023, 9, 460. [Google Scholar] [CrossRef] [PubMed]
- Singh, S.; Kumar, V.; Dhanjal, D.S.; Singh, J. Biological Control Agents: Diversity, Ecological Significances, and Biotechnological Applications. In Natural Bioactive Products in Sustainable Agriculture; Singh, J., Yadav, A.N., Eds.; Springer: Singapore, 2020; pp. 31–44. [Google Scholar]
- Thambugala, K.M.; Daranagama, D.A.; Phillips, A.J.L.; Kannangara, S.D.; Promputtha, I. Fungi vs. Fungi in Biocontrol: An Overview of Fungal Antagonists Applied Against Fungal Plant Pathogens. Front. Cell. Infect. Microbiol. 2020, 10, 604923. [Google Scholar] [CrossRef]
- Druzhinina, I.S.; Seidl-Seiboth, V.; Herrera-Estrella, A.; Horwitz, B.A.; Kenerley, C.M.; Monte, E.; Mukherjee, P.K.; Zeilinger, S.; Grigoriev, I.V.; Kubicek, C.P. Trichoderma: The genomics of opportunistic success. Nat. Rev. Microbiol. 2011, 9, 749–759. [Google Scholar] [CrossRef]
- Harman, G.E.; Howell, C.R.; Viterbo, A.; Chet, I.; Lorito, M. Trichoderma species—Opportunistic, avirulent plant symbionts. Nat. Rev. Microbiol. 2004, 2, 43–56. [Google Scholar] [CrossRef]
- Xu, H.; Yan, L.; Zhang, M.; Chang, X.; Zhu, D.; Wei, D.; Naeem, M.; Song, C.; Wu, X.; Liu, T.; et al. Changes in the Density and Composition of Rhizosphere Pathogenic Fusarium and Beneficial Trichoderma Contributing to Reduced Root Rot of Intercropped Soybean. Pathogens 2022, 11, 478. [Google Scholar] [CrossRef]
- Saravanakumar, K.; Li, Y.; Yu, C.; Wang, Q.-Q.; Wang, M.; Sun, J.; Gao, J.-X.; Chen, J. Effect of Trichoderma harzianum on maize rhizosphere microbiome and biocontrol of Fusarium Stalk rot. Sci. Rep. 2017, 7, 1771. [Google Scholar] [CrossRef] [PubMed]
- Alizadeh, F.; Abdullah, S.N.; Khodavandi, A.; Abdullah, F.; Yusuf, U.K.; Chong, P.P. Differential expression of oil palm pathology genes during interactions with Ganoderma boninense and Trichoderma harzianum. J. Plant Physiol. 2011, 168, 1106–1113. [Google Scholar] [CrossRef]
- Angel, L.P.; Yusof, M.T.; Ismail, I.S.; Ping, B.T.; Mohamed Azni, I.N.; Kamarudin, N.H.; Sundram, S. An in vitro study of the antifungal activity of Trichoderma virens 7b and a profile of its non-polar antifungal components released against Ganoderma boninense. J. Microbiol. 2016, 54, 732–744. [Google Scholar] [CrossRef] [PubMed]
- Naher, L.; Tan, S.G.; Ho, C.L.; Yusuf, U.K.; Ahmad, S.H.; Abdullah, F. mRNA expression of EgCHI1, EgCHI2, and EgCHI3 in oil palm leaves (Elaeis guineesis Jacq.) after treatment with Ganoderma boninense pat. and Trichoderma harzianum Rifai. Sci. World J. 2012, 2012, 647504. [Google Scholar] [CrossRef] [PubMed]
- Wang, Y.; Zeng, L.; Wu, J.; Jiang, H.; Mei, L. Diversity and effects of competitive Trichoderma species in Ganoderma lucidum-cultivated soils. Front. Microbiol. 2022, 13, 1067822. [Google Scholar] [CrossRef]
- Go, W.Z.; Chin, K.L.; H’Ng, P.S.; Wong, M.Y.; Lee, C.L.; Khoo, P.S. Exploring the Biocontrol Efficacy of Trichoderma spp. against Rigidoporus microporus, the Causal Agent of White Root Rot Disease in Rubber Trees (Hevea brasiliensis). Plants 2023, 12, 1066. [Google Scholar] [CrossRef]
- Chou, H.; Xiao, Y.T.; Tsai, J.N.; Li, T.T.; Wu, H.Y.; Liu, L.D.; Tzeng, D.S.; Chung, C.L. In Vitro and in Planta Evaluation of Trichoderma asperellum TA as a Biocontrol Agent Against Phellinus noxius, the Cause of Brown Root Rot Disease of Trees. Plant Dis. 2019, 103, 2733–2741. [Google Scholar] [CrossRef]
- Li, X.; Leng, J.; Yu, L.; Bai, H.; Li, X.; Wisniewski, M.; Liu, J.; Sui, Y. Efficacy of the biocontrol agent Trichoderma hamatum against Lasiodiplodia theobromae on macadamia. Front. Microbiol. 2022, 13, 994422. [Google Scholar] [CrossRef]
- Marraschi, R.; Ferreira, A.B.M.; da Silva Bueno, R.N.; Leite, J.; Lucon, C.M.M.; Harakava, R.; Leite, L.G.; Padovani, C.R.; Bueno, C.J. A protocol for selection of Trichoderma spp. to protect grapevine pruning wounds against Lasiodiplodia theobromae. Braz. J. Microbiol. 2019, 50, 213–221. [Google Scholar] [CrossRef]
- Burcham, D.C.; Abarrientos, N.V.; Wong, J.Y.; Ali, M.I.M.; Fong, Y.K.; Schwarze, F.W.M.R. Field evaluation of Trichoderma spp. as a biological control agent to prevent wood decay on Benin mahogany (Khaya grandifoliola) and rain tree (Samanea saman) in Singapore. Biol. Control 2017, 114, 114–124. [Google Scholar] [CrossRef]
- Pryce, T.M.; Palladino, S.; Kay, I.D.; Coombs, G.W. Rapid identification of fungi by sequencing the ITS1 and ITS2 regions using an automated capillary electrophoresis system. Med. Mycol. 2003, 41, 369–381. [Google Scholar] [CrossRef]
- Singh, J.; Kumar, V.; Srivastava, S.; Kumar, A.; Singh, V.P. In vitro Evaluation of Trichoderma Species Against Fusarium oxysporum f. sp. lycopersici Causing Tomato Wilt. Plant Pathol. J. 2018, 17, 59–64. [Google Scholar] [CrossRef]
- Dennis, C.; Webster, J. Antagonistic properties of species-groups of Trichoderma: II. Production of volatile antibiotics. Trans. Br. Mycol. Soc. 1971, 57, 41–48. [Google Scholar] [CrossRef]
- Intana, W.; Kheawleng, S.; Sunpapao, A. Trichoderma asperellum T76-14 Released Volatile Organic Compounds against Postharvest Fruit Rot in Muskmelons (Cucumis melo) Caused by Fusarium incarnatum. J. Fungi 2021, 7, 46. [Google Scholar] [CrossRef] [PubMed]
- Cheng, C.-H.; Yang, A.; Peng, K.-C. Antagonism of Trichoderma harzianum ETS 323 on Botrytis cinerea Mycelium in Culture Conditions. Phytopathology 2012, 102, 1054–1063. [Google Scholar] [CrossRef] [PubMed]
- Latha, P.; Prakasam, V.; Kamalakannan, A.; Gopalakrishnan, C.; Raguchander, T.; Paramathma, M.; Samiyappan, R. First report of Lasiodiplodia theobromae (Pat.) Griffon & Maubl causing root rot and collar rot disease of physic nut (Jatropha curcas L.) in India. Australas. Plant Dis. Notes 2009, 4, 19–20. [Google Scholar] [CrossRef]
- Sowmya, P.; Naik, V.N.; Sivaprasad, V.; Naik, V.G. Characterization and correlation of pathogenicity of Botryodiplodia theobromae isolates, the causal agent of black root rot of mulberry (Morus spp.). Arch. Phytopathol. Plant Prot. 2018, 51, 1022–1038. [Google Scholar] [CrossRef]
- Kanyakumari, R.; Somasekhara, Y.M.; Basavaraj, S.; Deeksha, M.G. Morpho-Molecular Identification of Lasiodiplodia theobromae Causing Root Rot of Mulberry in India. Natl. Acad. Sci. Lett. 2022, 45, 451–456. [Google Scholar] [CrossRef]
- Kwolek-Mirek, M.; Zadrag-Tecza, R. Comparison of methods used for assessing the viability and vitality of yeast cells. FEMS Yeast Res. 2014, 14, 1068–1079. [Google Scholar] [CrossRef]
- Howell, C.R. Mechanisms Employed by Trichoderma Species in the Biological Control of Plant Diseases: The History and Evolution of Current Concepts. Plant Dis. 2003, 87, 4–10. [Google Scholar] [CrossRef]
- Phoka, N.; Suwannarach, N.; Lumyong, S.; Ito, S.-I.; Matsui, K.; Arikit, S.; Sunpapao, A. Role of Volatiles from the Endophytic Fungus Trichoderma asperelloides PSU-P1 in Biocontrol Potential and in Promoting the Plant Growth of Arabidopsis thaliana. J. Fungi 2020, 6, 341. [Google Scholar] [CrossRef] [PubMed]
- Ruangwong, O.-U.; Wonglom, P.; Suwannarach, N.; Kumla, J.; Thaochan, N.; Chomnunti, P.; Pitija, K.; Sunpapao, A. Volatile Organic Compound from Trichoderma asperelloides TSU1: Impact on Plant Pathogenic Fungi. J. Fungi 2021, 7, 187. [Google Scholar] [CrossRef] [PubMed]
- Vukovic, N.; Milosevic, T.; Sukdolak, S.; Solujic, S. Antimicrobial Activities of Essential Oil and Methanol Extract of Teucrium montanum. Evid. Based Complement. Altern. Med. 2007, 4, 17–20. [Google Scholar] [CrossRef]
- Ferreira, O.O.; da Silva, S.H.M.; de Oliveira, M.S.; Andrade, E.H.A. Chemical Composition and Antifungal Activity of Myrcia multiflora and Eugenia florida Essential Oils. Molecules 2021, 26, 7259. [Google Scholar] [CrossRef]
- Majdabadi, N.; Falahati, M.; Heidarie-Kohan, F.; Farahyar, S.; Rahimi-Moghaddam, P.; Ashrafi-Khozani, M.; Razavi, T.; Mohammadnejad, S. Effect of 2-Phenylethanol as Antifungal Agent and Common Antifungals (Amphotericin B, Fluconazole, and Itraconazole) on Candida Species Isolated from Chronic and Recurrent Cases of Candidal Vulvovaginitis. Assay Drug Dev. Technol. 2018, 16, 141–149. [Google Scholar] [CrossRef]
- Siddiquee, S.; Cheong, B.E.; Taslima, K.; Kausar, H.; Hasan, M.M. Separation and Identification of Volatile Compounds from Liquid Cultures of Trichoderma harzianum by GC-MS using Three Different Capillary Columns. J. Chromatogr. Sci. 2012, 50, 358–367. [Google Scholar] [CrossRef]
- Chóez-Guaranda, I.; Espinoza-Lozano, F.; Reyes-Araujo, D.; Romero, C.; Manzano, P.; Galarza, L.; Sosa, D. Chemical Characterization of Trichoderma spp. Extracts with Antifungal Activity against Cocoa Pathogens. Molecules 2023, 28, 3208. [Google Scholar] [CrossRef]
- Yassin, M.T.; Mostafa, A.A.-F.; Al-Askar, A.A. In vitro antagonistic activity of Trichoderma harzianum and T. viride strains compared to carbendazim fungicide against the fungal phytopathogens of Sorghum bicolor (L.) Moench. Egypt. J. Biol. Pest Control 2021, 31, 118. [Google Scholar] [CrossRef]
- Stracquadanio, C.; Quiles, J.M.; Meca, G.; Cacciola, S.O. Antifungal Activity of Bioactive Metabolites Produced by Trichoderma asperellum and Trichoderma atroviride in Liquid Medium. J. Fungi 2020, 6, 263. [Google Scholar] [CrossRef]
- Mukherjee, M.; Mukherjee, P.K.; Horwitz, B.A.; Zachow, C.; Berg, G.; Zeilinger, S. Trichoderma–Plant–Pathogen Interactions: Advances in Genetics of Biological Control. Indian J. Microbiol. 2012, 52, 522–529. [Google Scholar] [CrossRef] [PubMed]
- Mukhopadhyay, R.; Kumar, D. Trichoderma: A beneficial antifungal agent and insights into its mechanism of biocontrol potential. Egypt. J. Biol. Pest Control 2020, 30, 133. [Google Scholar] [CrossRef]

| Components | Quantities Added |
|---|---|
| 0.03 g/mL Streptomycin | 800 µL |
| 0.1 g/mL Ampicillin | 800 µL |
| MilliQ Water | 800 mL |
| Potato Dextrose Agar Powder | 31.20 g |
| Sample ID (Abbreviation, Code) | Molecular Identify | GenBank Accession Number | Isolation Source |
|---|---|---|---|
| CE92FB_1C2G6B (CE92, Th-1) | Trichoderma harzianum | OQ789693 | A Fulvifomes siamensis fruiting body collected from a Casuarina equisetifolia tree, West Singapore |
| SSK1-A12AG2 (SSK1, Th-2) | Trichoderma harzianum | OQ789697 | A Ganoderma sp. fruiting body collected from an unidentified tree in Singapore Botanic Gardens |
| W2-5G2 (W2-5, Th-3) | Trichoderma harzianum | OQ789699 | A Ganoderma boninense fruiting body collected from a MacArthur Palm (Ptychosperma macarthurii), Central Singapore |
| 10-11BBG2 (10-11B) | Trichoderma harzianum | OQ789692 | A Ganoderma boninense fruiting body collected from a sealing wax palm (Cyrtostachys renda), Central Singapore |
| I36G2B (I36) | Trichoderma harzianum | OQ789695 | Soil of Brassica rapa cv. Caixin, West Singapore |
| I35G2 (I35) | Trichoderma harzianum | OQ789694 | Soil of Brassica rapa cv. Caixin, West Singapore |
| I41G3 (I41) | Trichoderma harzianum | OQ789696 | Soil of Amaranthus tricolor, West Singapore |
| KS71DT7G14 (H-Pn) | Phellinus noxius | OQ558864 | Khaya Tree (Khaya senegalensis) diseased tissue, West Singapore |
| YF37#2AG29 (H-Fs) | Fulvifomes siamensis | OQ618213 | A fruiting body on a Yellow Flame tree (Peltophorum pterocarpum), Central Singapore |
| PM162DT1-2G4 (H-Lt) | Lasiodiplodia theobromae | OQ558857 | Diseased tissue collected from a Purple Millettia tree (Callerya atropurpurea), Central Singapore |
| P167FBAG6 (H-Go) | Ganoderma orbiforme | OQ558851 | A fruiting body collected from a foxtail palm (Wodyetia bifurcate), Central Singapore |
| P172FB2G1 (H-Ga) | Ganoderma australe | OQ558853 | A fruiting body collected from an Areca palm (Dypsis lutescens), West Singapore |
| P175FB2G2 (H-Rm) | Rigidoporus microporus | OQ558869 | A fruiting body collected from a cabbage palm (Roystonea oleracea), West Singapore |
Disclaimer/Publisher’s Note: The statements, opinions and data contained in all publications are solely those of the individual author(s) and contributor(s) and not of MDPI and/or the editor(s). MDPI and/or the editor(s) disclaim responsibility for any injury to people or property resulting from any ideas, methods, instructions or products referred to in the content. |
© 2023 by the authors. Licensee MDPI, Basel, Switzerland. This article is an open access article distributed under the terms and conditions of the Creative Commons Attribution (CC BY) license (https://creativecommons.org/licenses/by/4.0/).
Share and Cite
Chan, M.E.; Tan, J.Y.; Lee, Y.Y.; Lee, D.; Fong, Y.K.; Mutwil, M.; Wong, J.Y.; Hong, Y. Locally Isolated Trichoderma harzianum Species Have Broad Spectrum Biocontrol Activities against the Wood Rot Fungal Species through Both Volatile Inhibition and Mycoparasitism. J. Fungi 2023, 9, 675. https://doi.org/10.3390/jof9060675
Chan ME, Tan JY, Lee YY, Lee D, Fong YK, Mutwil M, Wong JY, Hong Y. Locally Isolated Trichoderma harzianum Species Have Broad Spectrum Biocontrol Activities against the Wood Rot Fungal Species through Both Volatile Inhibition and Mycoparasitism. Journal of Fungi. 2023; 9(6):675. https://doi.org/10.3390/jof9060675
Chicago/Turabian StyleChan, Mu En, Jhing Yein Tan, Yan Yi Lee, Daryl Lee, Yok King Fong, Marek Mutwil, Jia Yih Wong, and Yan Hong. 2023. "Locally Isolated Trichoderma harzianum Species Have Broad Spectrum Biocontrol Activities against the Wood Rot Fungal Species through Both Volatile Inhibition and Mycoparasitism" Journal of Fungi 9, no. 6: 675. https://doi.org/10.3390/jof9060675
APA StyleChan, M. E., Tan, J. Y., Lee, Y. Y., Lee, D., Fong, Y. K., Mutwil, M., Wong, J. Y., & Hong, Y. (2023). Locally Isolated Trichoderma harzianum Species Have Broad Spectrum Biocontrol Activities against the Wood Rot Fungal Species through Both Volatile Inhibition and Mycoparasitism. Journal of Fungi, 9(6), 675. https://doi.org/10.3390/jof9060675

